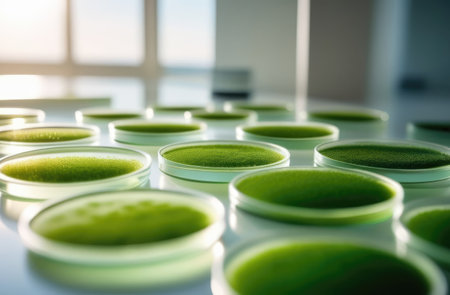
Algae, microalgae in petri dishes research in laboratories. biotechnology, science. Macro. Biofuel research process in laboratory. Generative AIの素材

素材 - Algae, microalgae in petri dishes research in laboratories. biotechnology, science. Macro. Biofuel research process in laboratory. Generative AI
作品情報
Algae, microalgae in petri dishes research in laboratories. biotechnology, science. Macro. Biofuel research process in laboratory. Generative AI
- ID:272194064
- 作品種別:
- 作者名:iloli
キーワード
- alga
- algae
- alternative
- background
- biodiesel
- biofuel
- biology
- biotechnology
- bottle
- cell
- color
- control
- culture
- education
- energy
- environment
- equipment
- experiment
- extraction
- fuel
- generative ai
- green
- industrial
- industry
- lab
- laboratory
- life
- light
- marine
- microalgae
- natural
- nutritious
- oil
- photobioreactor
- plant
- plastic
- plate
- process
- production
- research
- sample
- science
- scientific
- small
- study
- sustainable
- system
- technology
- tool
類似作品
Algae, microalg...
Algae, microalg...
Algae, microalg...
Algae, microalg...
Algae, microalg...
liquid micro al...
Clusters of gre...
Laboratory glas...
Algae, microalg...
Exploring micro...
Scientific rese...
Algae, microalg...
Scientist hand ...
Algae, microalg...
Algae, microalg...
Laboratory glas...
Bright green mi...
Algae, microalg...
Petri dishes wi...
Algae, microalg...
Algae, microalg...
Vibrio parahaem...
Clusters of gre...
Algae, microalg...
Mixed of bacter...
Slant tubes and...
Close up of Pet...
Fungi colonies ...
Mold on a spoil...
Petri dish with...
research and Bi...
Algae, microalg...
white mold grow...
Petri dishes wi...
Algae, microalg...
Algae, microalg...
Genetically mod...
Close up of lot...
Culture in a pe...
Growth of diffe...
lab with unique...
A microscopic v...
Background with...
Algae, microalg...
Backgrounds of ...
Petri dishes fi...
organelles plan...
Genetically mod...
Culture in a pe...